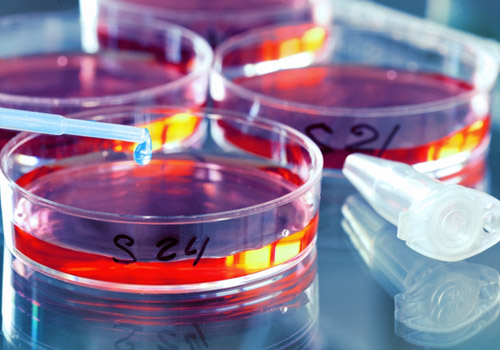

Our manufacturing plant at Noida is Good Manufacturing Practice (cGMP) compliant with the most modern state-of-art facility to manufacture therapeutic dosage forms of:





Navya Multi Trade Industries is universally respected among its clients for the deliverance of quality products. This level of trust is a result of company’s elaborate quality control systems which ensure only the best raw material is used in making every product. Herbal ingredients are thoroughly analyzed to select the material of the highest grade and quality, in-process material maintains the right process parameters
We believe in total quality management and total quality compliance, we provide validation through independent laboratory testing also.


Microbial standards including pathogens are tested

Invitro Studies
New project to manufacture an Ophthalmic range of products is under implementation.


